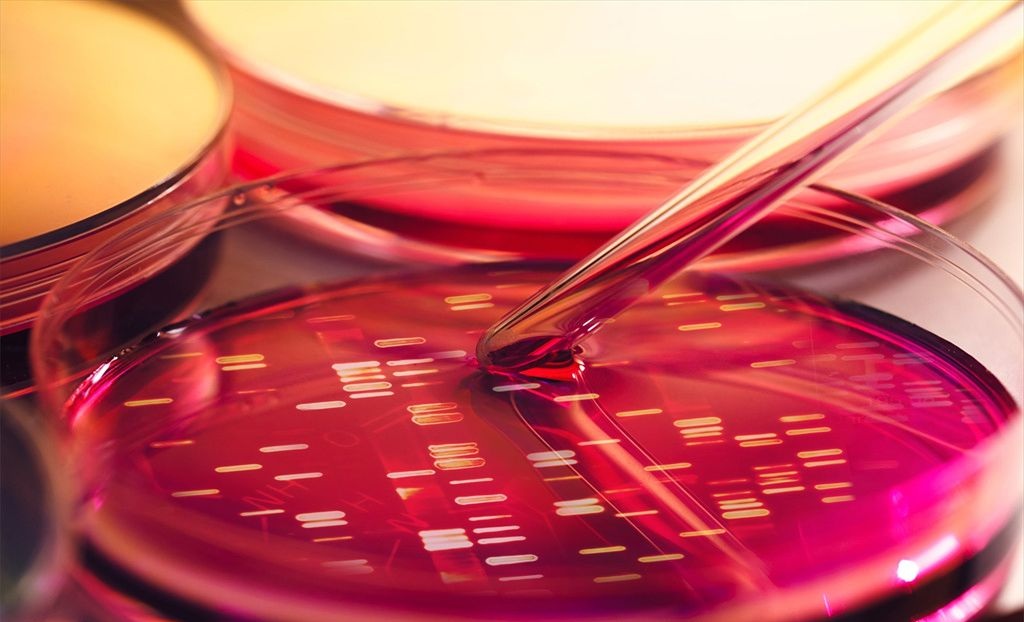
血緣關系鑒定

血緣關系鑒定是什么意思
血緣關系鑒定是什么意思?DNA親子鑒定方式大致可以分為兩種,分別是個人親子鑒定和司法親子鑒定。個人親子鑒定和司法親子鑒定存在顯著的區別,對被鑒定人的要求也不一樣。其中個人親子鑒定適合單純想知道鑒定結果的人群,司法親子鑒定適合需要讓外界承認的人群。
個人親子鑒定怎么做
個人親子鑒定也叫個人隱私親子鑒定,可以通過匿名郵寄鑒定樣本的方式完成。怎么做呢?委托人只需要聯系DNA親子鑒定中心,在工作人員的指導下,采集被鑒定人的樣本,然后郵寄到鑒定中心來,這樣就能完成個人隱私親子鑒定了。完成個人隱私親子鑒定的過程不需要提供任何證明本人身份的證件,也不需要到鑒定中心來,一些都可以通過線上解決。DNA親子鑒定中心保證個人隱私親子鑒定的結果的準確性,對所出具的鑒定結果負法律責任。
司法親子鑒定怎么做
司法親子鑒定又可以細分為上戶口親子鑒定、移民親子鑒定等,是具有司法效力的親子鑒定。司法親子鑒定需要提前預約,然后攜帶證明本人身份的證件(身份證、戶口本、護照、駕駛證、出生證明等),委托書到鑒定中心來采樣辦理。DNA親子鑒定中心的工作人員會現場核驗所有被鑒定人的身份,并拍照錄指紋等。委托書可以自己攜帶單位委托書或者到鑒定現場填寫個人委托書,同樣需要簽字錄指紋。司法親子鑒定只能實名辦理,DNA親子鑒定中心可以保證出具的鑒定報告被國內外公檢法認可和解讀。
不管是做個人親子鑒定還是司法親子鑒定,都建議選擇正規有資質的鑒定機構。DNA親子鑒定中心作為國內知名親子鑒定機構,在全國各地都設有分部,可以接收來自全國的親子鑒定案例,保證鑒定結果的準確性。
標簽:血緣關系鑒定


微信掃碼咨詢預約